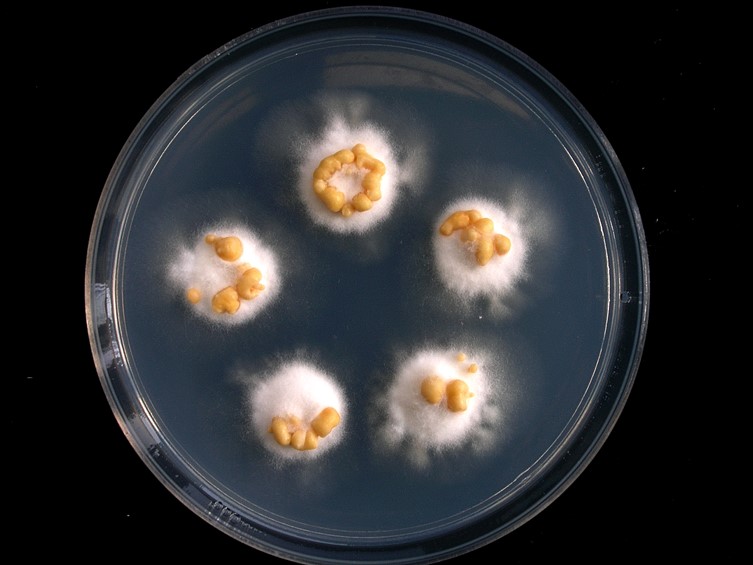

Habitat:
Underside of dicotyledonous leaves, twig of trees.
Host:
Whiteflies (Aleyrodidae).
Description:
 Sexual morph: stromata circular to oval, consisting of dense interlaced mycelial mat, sometimes margin surrounded by membranous hypothallus, up to 6 mm diam, white, pale yellow or orange.
Sexual morph: stromata circular to oval, consisting of dense interlaced mycelial mat, sometimes margin surrounded by membranous hypothallus, up to 6 mm diam, white, pale yellow or orange.  Perithecium in tubercles, erect, solitary or aggregated, arising from the stroma, each tubercle containing one perithecium, perithecia elongated flask-shaped, with a long neck, sometimes ovoid or irregular, 300-450 µm deep, 125-360 µm diam.
Perithecium in tubercles, erect, solitary or aggregated, arising from the stroma, each tubercle containing one perithecium, perithecia elongated flask-shaped, with a long neck, sometimes ovoid or irregular, 300-450 µm deep, 125-360 µm diam.  Asci cylindrical, up to 450 µm long, ca 6.5-15 µm diam, with a distinct, thickened hyaline cap 7.5-9 µm long, 7.5-10 µm diam.
Asci cylindrical, up to 450 µm long, ca 6.5-15 µm diam, with a distinct, thickened hyaline cap 7.5-9 µm long, 7.5-10 µm diam.  Ascospores divide into part-spores, cylindrical narrow-oval, tapering slightly towards the ends, ends somewhat rounded to obtuse, 10-16 × 2.5-4 µm, sometimes slightly curved.
Ascospores divide into part-spores, cylindrical narrow-oval, tapering slightly towards the ends, ends somewhat rounded to obtuse, 10-16 × 2.5-4 µm, sometimes slightly curved.  Asexual morph: stromata variable, usually circular, flattened pulvinate and widely open, often irregular, rarely discoid, 0.5-4 mm diam, ca 1-1.5 mm high, white to yellow-white, base surrounded by dense mycelium, often more or less covered by a copious mass of extruded
Asexual morph: stromata variable, usually circular, flattened pulvinate and widely open, often irregular, rarely discoid, 0.5-4 mm diam, ca 1-1.5 mm high, white to yellow-white, base surrounded by dense mycelium, often more or less covered by a copious mass of extruded  conidia, pale yellow to light orange or orange.
conidia, pale yellow to light orange or orange.  Conidiomata pycnidial, embedded in stroma, circular, ovoid or irregular, up to 250 µm diam.
Conidiomata pycnidial, embedded in stroma, circular, ovoid or irregular, up to 250 µm diam.  Paraphyses present, linear up to 80 µm long.
Paraphyses present, linear up to 80 µm long.  Phialides cylindrical, up to 50 µm. Conidia narrow-oval, tapering slightly towards the ends, 12-14 × 2-2.5 µm. The conidia of Thai specimens were longer and wider than those described by Petch (1921) (10-14 × 1.5-2 µm).
Phialides cylindrical, up to 50 µm. Conidia narrow-oval, tapering slightly towards the ends, 12-14 × 2-2.5 µm. The conidia of Thai specimens were longer and wider than those described by Petch (1921) (10-14 × 1.5-2 µm).
Culture characteristics:
Colonies on PDA attaining a diam of 1 cm diam after 4 wk. The stromatic colonies were white. The yellow to orange colored conidial masses produced a scattered covering over the surface of the stromatic colonies after 4 wk.
Colonies on PDA attaining a diam of 1 cm diam after 4 wk. The stromatic colonies were white. The yellow to orange colored conidial masses produced a scattered covering over the surface of the stromatic colonies after 4 wk.
Reference:
Chaverri P, Liu M, Hodge KT (2008). A monograph of the entomopathogenic genera Hypocrella, Moelleriella, and Samuelsia gen. nov. (Ascomycota, Hypocreales, Clavicipitaceae), and their aschersonia-like anamorphs in the Neotropics. Studies in Mycology 60: 1–66.
DOI: https://dx.doi.org/10.3114/sim.2008.60.01Petch T (1921). Studies in entomogenous fungi: II. The genera Hypocrella and Aschersonia. Annals of the Royal Botanic Gardens Peradeniya 7: 167–278.
Species |
Strain |
Compound |
Pubchem CID |
Biological activity |
Reference |
|---|
|
Strain |
RPB1 | TEF1 |
|---|---|---|
| BCC 47597 | JQ269644 | KX254418 |
| BCC 48745 | JQ269642 | KX254420 |
| BCC 49361 | JQ269643 | KX254419 |